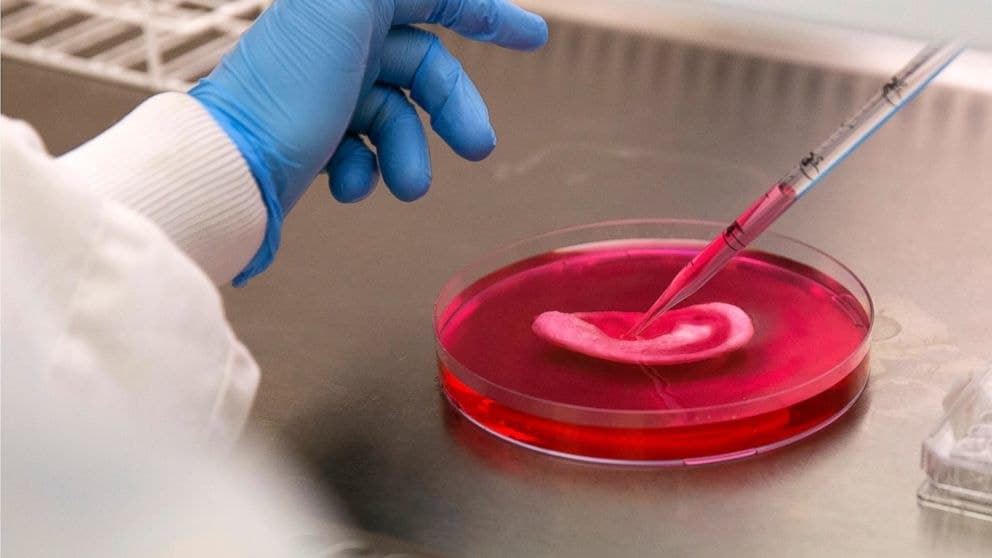
14 Future Inventions that the Scientists have been working on

Tech geeks here is something you all need to know about, some future inventions and what might come up in the future. These technologies will change the whole human existence. Let’s have a look at it.
1. The Future Is Now
It was just a few years back when we freaked out on the launch of video iPods, and now the kind of technology we have is more advanced. We now have google glasses, Snapchat glasses, and whatnot. This stuff signifies the current generation and scientists are working on more things like these. So we cannot wait to see more things that can freak us out again!

2. Bio-Bean
Who doesn’t love coffee? Coffee is somewhere the most consumed caffeine. But we got some earth-conscious coffee consumers; this new invention is for you people: Bio-Bean. A London based company recycles the waste coffee grounds into “Biomass pellets” and biochemicals. The recycled waste can be used for heating and power transport.

3. Anti-aging
Not those big named moisturizing creams and serums that worked but had side effects too, but we got something more significant. Might be by 2030, we get something that would reverse or slow down the impact of aging.
Big companies have started to invest in the research and have got so much confidence in it. Calico, a company that was started by Google’s co-founder Larry Page, who claims that his study and its outcome aim to extend the human lifespan by a century. Many big firms like Facebook, Amazon, Apple and many more have invested large sums in this anti-aging research.

4. Lab-Grown Organs
Wake Forest Institute of Regenerative Medicine has researchers that have been working in a lab to grow various human body parts out of human cells.
Researchers use a small part of the patient’s organ and separate out different cells to let them multiply, and all the research is going on in a lab setting. They make the cells sit in a fluid for the specific period and then pour them into scaffolds and incubate it before placing it into the human body as a new organ.
5. The Deka Arm
Deka Arm is an all-new invention. We all know about the prosthetic limbs, but this is entirely different and new, the first mind-controlled prosthetic arm is here. Micro electricity has powered the arm, the Deka Arm “senses movement in various muscle groups via attached electrodes, then converts those movements into motor control.”
The arm was recently approved by the FDA, which claims that it is out for sale, but the cost is quite hard to get, as it reaches for about $50,000. Quite an expensive deal.

6. Interplanetary Internet
We knew there is life on Mars, and moving to the planet seems to be right around the corner. What if we start living there? We need the internet too! Well! The next step is the interplanetary internet.
Google’s “chief internet evangelist” Vint Cerf has been working with NASA to develop protocols to bring internet to space. Things are easier said than being done; it will be utterly different if space has the internet as it might affect the other aspects including the speed of light!
But Cerf is very much confident about it; he says that “at the front end of what could be an evolving and expand interplanetary backbone.” You never know what comes next, what if we the astronauts working on the planet start to surf their Facebook and to watch cute videos on YouTube!

7. 3D Printing
This is something new and quite shocking to the ears. 3D printers are the nextgen printer. The creators believe that they will be there in every household in the future and they could print medications, and one doesn’t have to run the last minute to get them.
iRobot is the company that has been working on the “Robotic Fabricator,” which is the 3D printer that doesn’t need any human assistance. Just like the robots, the Robotic Fabricator can construct all its parts on their own. Isn’t it strange? Don’t know what more is to come!

8. The Titan Arm
The Titan’s arm was developed by the students of the University of Pennsylvania; it is an exoskeleton that can boost arm strength by 40 pounds. The idea to invent this arm was to help people in manual labor to prevent back problems and to increase efficiency in performing their jobs, and it is cost-effective too. It can also assist in physical therapy.

9. Active Contact Lenses
We have seen these lenses till now in the movies only, but they are here. The progressive lenses fit in just like the standard lenses and have the capacity to display different images like the screen of our smartphone, time or how much we walked. That directly shows up onto our retina. We can even watch movies without also opening our eyes.
It has taken a long time to develop progressive lenses, and many researchers worked on it. The most recent research of it comes from the University of Washington, where “Professor Babak Parviz has toyed with the idea of adding medical sensors to the lenses, which could monitor blood sugar levels in people with diabetes.”

10. PCell
With the growing population, our digital need also has been increasing. We have become more digital and wireless capacity is something of concern. Artemis Networks’ PCell concept claims to give every cell user full wireless capacity. Yes! They said so.
“They can be deployed in such a way that no one will be able to see them,” says Artemis CEO Steve Perlman. The PCell is very small and only 15 millimeters wide, and it can fit in our palm. They don’t need any permit to be installed. Isn’t that great?
Read also: Check out what might be the future of VR

11. Smart Jacket
Well, phones were smart, humans used to be, but now we got jackets that claim to be more intelligent than our smartphones. Levi’s and Google together are coming up with a smart jacket, a jean cloth jacket that connects with our smartphones via Bluetooth wrist cuff that is removable. It allows you to answer calls, let you know directions and also change your music. And you won’t believe it is machine washable!
It is said that the jacket will be on the market by the fall and will cost $350.

12. Hyperloop
Are you sick of commuting for long hours on a public bus? Here is something to your rescue: Hyperloop. Elon Musk, the creator of Hyperloop, claims that this transportation system is more effective than the ones we travel through. The transport resembles the trains, but it works at the speed of 600 Mph inside a tube. And it just takes 35 minutes to reach San Francisco from LA.
The estimated cost for this operation was $6 Billion – $3Billion less than the amount pledged for high-speed rail. The government should work on rational thinking and maintain the cost.

13. Mindflix
Lazy lads here is a new gadget in the market for you: “Mindflix”. A team of engineers at the Netflix hackathon came up with their creation of Mindflix, a mind-controlled headband that works with the brain signals to choose what you want to see on Netflix and it is hands-free.
Unfortunately, Netflix has no plans to launch this technology in the market, but it should, as it would make them earn more!

14. Flexible Touchpad
We have projectors but ever thought of watching something on your body part? This new technology can help you do that. The researcher has been working on developing a flexible display that can be inserted into the clothing or even on the human body.
“This is the first time anyone has made a transparent, touch-sensitive electronic device that can detect touch while the device is being bent or stretched,” says John Madden, an electrical engineer at the University of British Columbia. It can be a cost-effective product, as it is seen that the material used in its creation is quite cheap. So, who all ar3e ready to buy the product?




